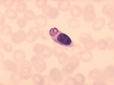
Sıtma Mikrobu Belirtileri

Virüsler hangi hastalıklara yol açar?
Virüsler, canlı hücrelerde çoğalan ve birçok hastalığa yol açabilen mikroskobik organizmalardır. Bu yazıda, virüslerin tanımı, genel özellikleri ve neden olduğu başlıca hastalıklar ele alınacaktır. Ayrıca, virüslerin bulaşma yolları ve toplum sağlığı üzerindeki etkileri üzerinde durulacak.
Virüsler, canlı hücrelerde çoğalabilen ve çoğu zaman hastalıklara yol açabilen mikroskopik organizmalardır. İnsan sağlığı üzerinde önemli etkilere sahip olan virüsler, çeşitli hastalıkların etken maddesi olarak karşımıza çıkmaktadır. Bu makalede, virüslerin neden olduğu başlıca hastalıklar ve bu hastalıkların etiyolojisi üzerinde durulacaktır.Virüslerin Tanımı ve Genel ÖzellikleriVirüsler, genetik materyali (DNA veya RNA) bir kapsid ile çevrili olan ve dış ortamda bağımsız olarak yaşam süremeyen enfeksiyöz ajanlardır. Virüslerin temel özellikleri şunlardır:
Virüsler, insanlardaki hastalıkları etkileyerek bağışıklık sistemini zayıflatabilir ve bu da çeşitli sağlık sorunlarına yol açabilir. Virüslerin Neden Olduğu Başlıca HastalıklarVirüslerin neden olduğu hastalıklar, genellikle bulaşıcıdır ve toplum sağlığı açısından ciddi tehditler oluşturabilir. Aşağıda, virüslerin neden olduğu en yaygın hastalıklardan bazıları sıralanmaktadır:
Virüs Bulaşma YollarıVirüslerin bulaşma yolları, hastalığın yayılımını etkileyen önemli bir faktördür. Virüsler genellikle aşağıdaki yollarla bulaşabilir:
SonuçVirüsler, insan sağlığı üzerinde önemli tehditler oluşturmakta ve birçok hastalığa yol açmaktadır. Grip, HIV, hepatit ve COVID-19 gibi hastalıklar, toplum sağlığını doğrudan etkileyen başlıca virüs kaynaklı hastalıklardır. Bu nedenle, virüslerin yayılımını önlemek için hijyen kurallarına uymak, aşı olmak ve sağlık hizmetlerine erişim sağlamak önemlidir. Virüslerle mücadelede toplum bilincinin artırılması, bu hastalıkların etkilerini azaltmak için kritik bir adımdır. Ekstra BilgilerVirüslerin araştırılması, tıbbi ve biyolojik bilimlerde önemli bir alan teşkil etmektedir. Aşı geliştirme çalışmaları, virüslerin neden olduğu hastalıkların önlenmesinde kritik bir rol oynamaktadır. Ayrıca, antiviral tedavi yöntemleri, bu hastalıkların tedavisinde kullanılmaktadır. Toplum sağlığının korunması ve hastalıkların kontrol altına alınması amacıyla, virüsler hakkında farkındalığın artırılması ve eğitim programlarının düzenlenmesi gerekmektedir. |